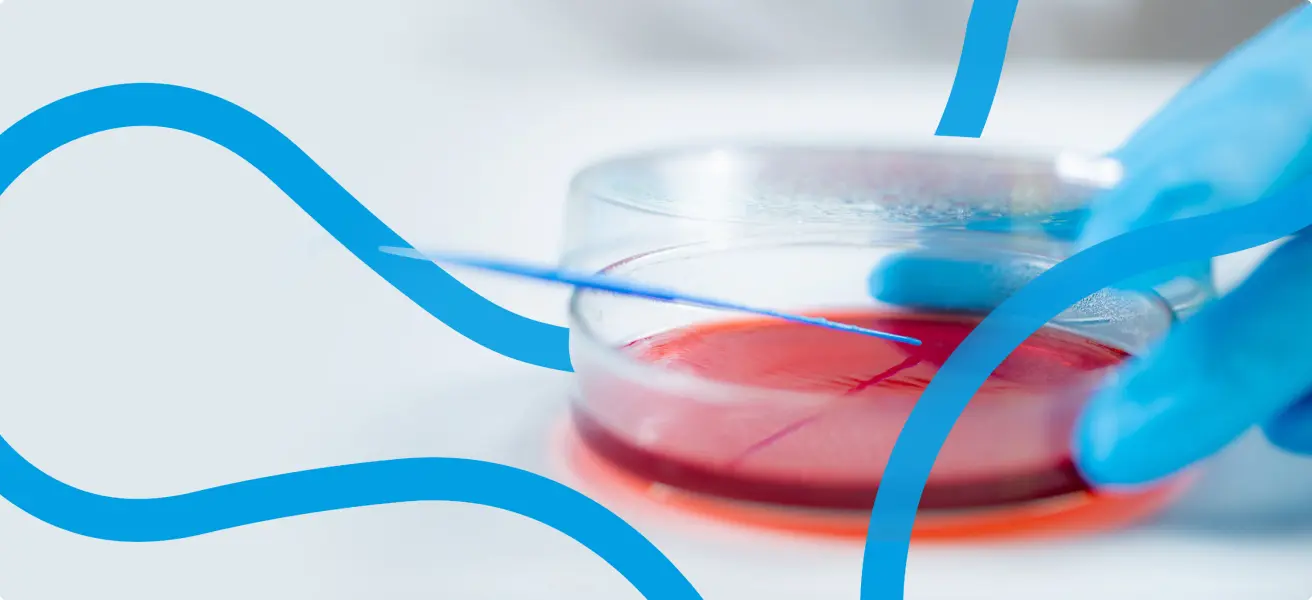
Badania mikrobiologiczne

Badanie mikrobiologiczne ma na celu wykrycie drobnoustroju chorobotwórczego w materiale klinicznym oraz oznaczenie jego wrażliwości na antybiotyki (antybiogram, mykogram).
Badanie mikrobiologiczne jest procesem wieloetapowym.
Zgodnie z zaleceniem Konsultanta Krajowego w dziedzinie mikrobiologii lekarskiej, w roku 2011 wprowadzone zostały nowe zasady interpretacji wyników oznaczania lekowrażliwości drobnoustrojów – zalecenia EUCAST (więcej informacji na www.korld.edu.pl)
wynik badania jest wydawany, jeśli zakończony zostanie proces identyfikacji drobnoustroju i oznaczona zostanie jego wrażliwość na leki.
wynik badania jest wydawany, jeśli po określonym czasie inkubacji nie stwierdza się wzrostu drobnoustrojów (zwykle 24-48 godzin, w przypadku posiewu krwi oraz płynu mózgowo-rdzeniowego 5 dni).
Zadbaj z nami o zdrowie - zapisz się na newsletter!
Otrzymuj praktyczne informacje na temat profilaktyki i badań laboratoryjnych, dzięki którym poszerzysz swoją wiedzę na temat świadomej troski o zdrowie. Zapisz się na newsletter i odbierz -20% zniżki na kolejny zakup w e-sklepie.